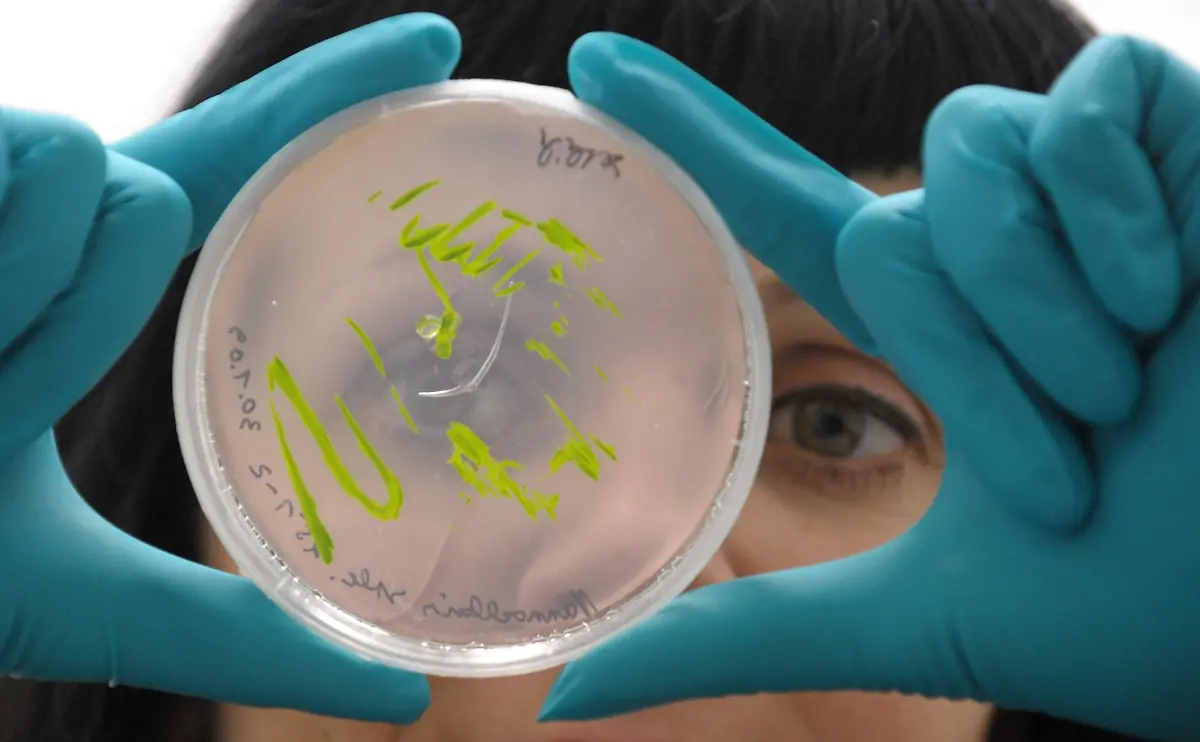
alzheimer-gr-II

Bilderserien

Glitschiges Gestrüpp?Algen können mehr
04.06.2009, 10:13 Uhr
Algen taugen als Alleskönner. Sie können im Gebäck für die besondere Farbe, beim Sushi für den besonderen Geschmack, als Salat für die Deckung des Jodbedarfs sorgen oder in großen Anlagen industriell vielfach genutzt werden. Manche Arten sind allerdings auch hochgiftig.